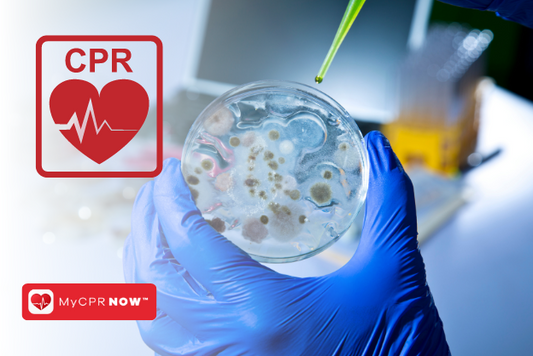
Bloodborne Pathogens Certification: A Must for Every Workplace

MyCPR NOW Blog

The Top Benefits of CPR Certification for Nurses
As a healthcare professional and a nurse, being prepared for any situation is critical. This includes having the knowledge and skills to perform cardiopulmonary resuscitation (CPR) in an emergency situation....
Read MoreThe Top Benefits of CPR Certification for Nurses
As a healthcare professional and a nurse, being prepared for any situation is critical. This includes having the knowledge and skills to perform cardiopulmonary resuscitation (CPR) in an emergency situation....

CPR Certifications for Coaches
CPR certification is a vital component of being a responsible and effective coach. Blended learning is a flexible option for CPR certification courses, allowing participants to choose between in-person, online,...
Read MoreCPR Certifications for Coaches
CPR certification is a vital component of being a responsible and effective coach. Blended learning is a flexible option for CPR certification courses, allowing participants to choose between in-person, online,...

How You Can Save a Life in an Emergency
In an emergency situation, every second counts. Knowing how to perform cardiopulmonary resuscitation (CPR) can make all the difference in saving a life. CPR is a critical life-saving skill that...
Read MoreHow You Can Save a Life in an Emergency
In an emergency situation, every second counts. Knowing how to perform cardiopulmonary resuscitation (CPR) can make all the difference in saving a life. CPR is a critical life-saving skill that...

BBP Certification for Janitorial and Custodial Workers
Bloodborne Pathogens: An In-Depth Guide for Janitors and Custodians Janitors and custodians are at a heightened risk of exposure to bloodborne pathogens such as HIV, hepatitis B, and hepatitis C....
Read MoreBBP Certification for Janitorial and Custodial Workers
Bloodborne Pathogens: An In-Depth Guide for Janitors and Custodians Janitors and custodians are at a heightened risk of exposure to bloodborne pathogens such as HIV, hepatitis B, and hepatitis C....

How to Recognize the Signs of Heart Failure
Cardiac arrest is a sudden and life-threatening event where the heart abruptly stops beating, cutting off blood flow to the brain and other vital organs. This condition requires immediate action...
Read MoreHow to Recognize the Signs of Heart Failure
Cardiac arrest is a sudden and life-threatening event where the heart abruptly stops beating, cutting off blood flow to the brain and other vital organs. This condition requires immediate action...
Bloodborne Pathogens Certification: A Must for Every Workplace
Bloodborne pathogens are dangerous microorganisms found in human blood and body fluids that can cause diseases in humans. Some of the most well-known bloodborne pathogens include HIV (Human Immunodeficiency Virus),...
Read MoreBloodborne Pathogens Certification: A Must for Every Workplace
Bloodborne pathogens are dangerous microorganisms found in human blood and body fluids that can cause diseases in humans. Some of the most well-known bloodborne pathogens include HIV (Human Immunodeficiency Virus),...
